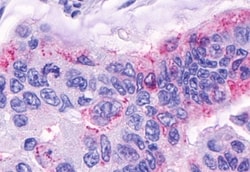
Invitrogen GPR120 Polyclonal Antibody 50 &mu;g; Unconjugated:Antibodies,

missing translation for 'onlineSavingsMsg'
Learn More
Learn More
Invitrogen™ GPR120 Polyclonal Antibody


Rabbit Polyclonal Antibody
Brand: Invitrogen™ PA534036
This item is not returnable.
View return policy
Description
This antibody is not recommended for use in ICC applications. Percent identity with other species by BLAST analysis: Human, Gorilla, Gibbon, Monkey, Bat, Elephant, Rabbit (94%) Marmoset, Mouse, Rat, Pig (89%).
An EST for GPR120 has been isolated from a human colon cancer library. G-protein Coupled Receptors (GPCRs) comprise one of the largest families of signaling molecules with more than a thousand members currently predicted to exist. All GPCRs share a structural motif consisting of seven membrane-spanning helices, and exist in both active and inactive forms. An array of activating ligands participate in the conformation of GPCRs which leads to signaling via G-proteins and downstream effectors. Ongoing studies have also shown the vast series of reactions which participate in the negative regulation of GPCRs. This turn-off activity has tremendous implications for the physiological action of the cell, and continues to drive pharmacological research for new drug candidates. Two blockbuster drugs which have been developed as GPCR-targeted pharmaceuticals are Zyprexa (Eli Lilly) and Claritin (Schering-Plough) which have multi-billion dollar shares of the mental health and allergy markets, respectively.
Specifications
| GPR120 | |
| Polyclonal | |
| Unconjugated | |
| FFAR4 | |
| AI552415; BMIQ10; FFAR4; Free fatty acid receptor 4; G protein-coupled receptor 120; GPCR120; Gpr120; Gpr129; G-protein coupled receptor 120; G-protein coupled receptor 129; G-protein coupled receptor GT01; G-protein coupled receptor PGR4; G-protein-coupled receptor GT01; GT01; KPG_013; O3FAR1; omega-3 fatty acid receptor 1; PGR4 | |
| Rabbit | |
| Antigen affinity chromatography | |
| RUO | |
| 338557 | |
| Store at 4°C short term. For long term storage, store at -20°C, avoiding freeze/thaw cycles. | |
| Liquid |
| Immunohistochemistry (Paraffin) | |
| 1 mg/mL | |
| PBS with 0.1% sodium azide | |
| Q5NUL3 | |
| FFAR4 | |
| Synthetic 18 amino acid peptide from 3rd cytoplasmic domain of human O3FAR1 / GPR120. | |
| 50 μg | |
| Primary | |
| Human | |
| Antibody | |
| IgG |
Product Content Correction
Your input is important to us. Please complete this form to provide feedback related to the content on this product.
Product Title
Spot an opportunity for improvement?Share a Content Correction